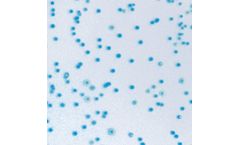
CHROMagar - E.coli
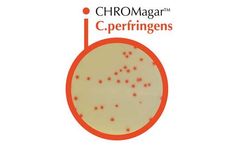
CHROMagar - Model C - Perfringens

- Home
- Equipment
Refine by
Chromagar Environmental Equipment & Supplies
6 equipment items found
by:CHROMagar based inParis, FRANCE
Performance: Contamination by faecal material from animals can be shown by the detection of Escherichia coli in the sample. E. coli can contaminate drinking water when the water treatment system is inadequate or during periods of very high rainfalls. Monitoring of food and water production is essential. High contamination may lead to the suspension of the water supply or food recall by ...
by:CHROMagar based inParis, FRANCE
Performance: Coliforms, Enterobacteriacae able to ferment lactose (lactose positive Enterobacteriacae), are bacteria present in human and warm blooded animals intestinal flora, in the soil and water. Coliforms are proof of organic, environmental or faecal contamination. Faecal contamination, due to coliforms coming from animal waste, consists mainly of Escherichia coli and thermotolerant ...
Manufactured by:Dalynn Biologicals based inCalgary, ALBERTA (CANADA)
Acinetobacter Agar Plate - 10 /package. Size ...
Manufactured by:DRG International, Inc. based inSpringfield, NEW JERSEY (USA)
CHROMagar™chromogenic plates are easy to prepare - just add water to the dehydrated media, bring to a boil, let it cool down and pour! Use the entire pack, or if there is a need for a smaller number of plates, just a portion. CHROMagar™ products are sold in dehydrated form. DRG offers the 5L size (after reconstitution). If kept under appropriate storage temperatures, CHROMagar™ ...
Manufactured by:Scharlab,S.L. based inSentmenat, Barcelona, SPAIN
Chromogenic dehydrated medium for detection and enumeration of Clostridium ...
by:CHROMagar based inParis, FRANCE
Performance: Coliforms, Enterobacteriacae able to ferment lactose (lactose positive Enterobacteriacae), are bacteria present not only in human and warm blooded animals intestinal flora but also in the soil and water. Coliforms are proof of organic, environmental or faecal contamination. Faecal contamination, due to coliforms coming from animal waste, consists mainly of Escherichia coli and ...